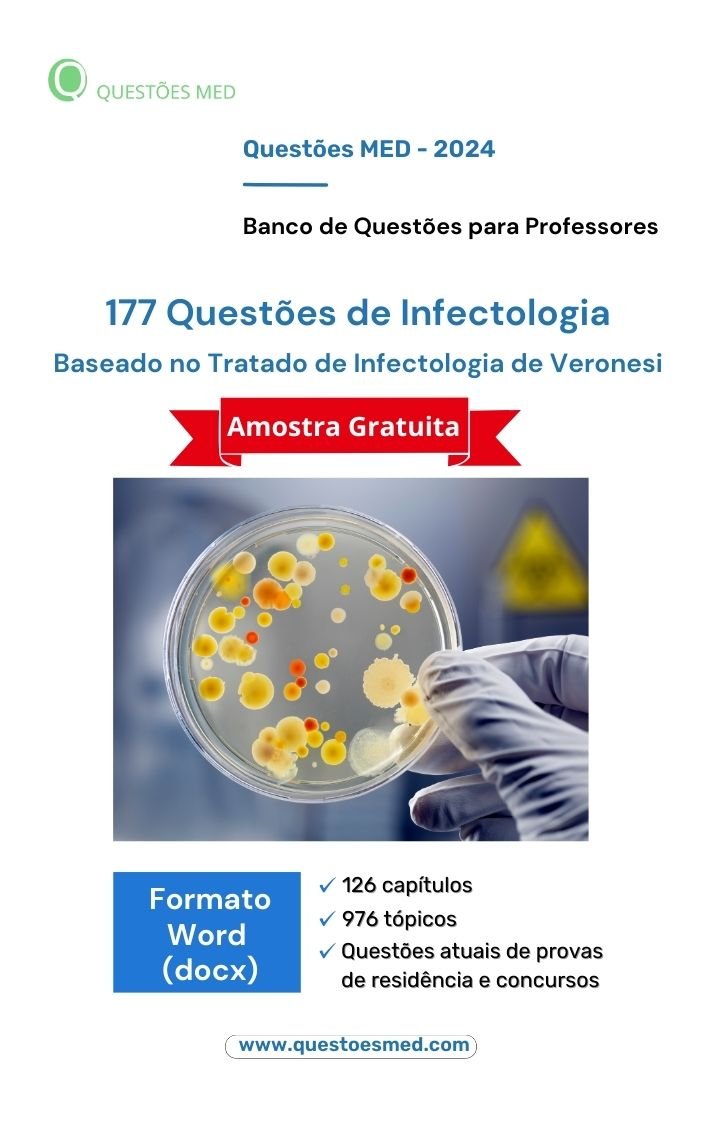

Banco de Questões MED criado para ser uma ferramenta indispensável para professores de medicina. Otimize e aprimore sua prática docente. Reduza o tempo de elaboração de provas e avaliações.
Assuntos cobertos:
Seção 1: Introdução à infectologia clínica (4 questões)
1. Fatores de virulência microbiana (0 questão)
2. Imunologia das doenças infecciosas (0 questão)
3. Infecções associadas à assistência à saúde: medidas de prevenção e controle (0 questão)
4. Imunizações (0 questão)
5. Antibióticos e antibioticoterapia: princípios gerais para sua utilização (0 questão)
6. Guia prático de antibióticos e antibioticoterapia (4 questões)
7. Resistência bacteriana a antimicrobianos (0 questão)
8. Exame do liquor nas doenças infecciosas (0 questão)
Seção 2: Vírus (69 questões)
9. Aids e infecção por HIV (12 questões)
10. Arboviroses (0 questão)
11. Caxumba (0 questão)
12. Enteroviroses (2 questões)
13. Dengue (10 questões)
16. Febre amarela (2 questões)
17. Febres hemorrágicas virais (1 questão)
18. Hantaviroses (1 questão)
19. Hepatites virais (13 questões)
20. Infecções por vírus herpes (10 questões)
21. Infecções causadas por vírus linfotrópicos de células T humanas (HTLV 1 e 2) (0 questão)
22. Infecções respiratórias virais (1 questão)
23. Neuroviroses (0 questão)
24. Papilomaviroses humanas (HPV) (3 questões)
25. Parvovírus eritema infeccioso (6 questões)
26. Raiva (2 questões)
27. Rotavirose e outras infecções por vírus entéricos (4 questões)
28. Rubéola (0 questão)
29. Sarampo (2 questões)
30. Varíola (0 questão)
Seção 3: Riquétsias (1 questão)
31. Febre maculosa brasileira e outras riquetsioses no Brasil (1 questão)
Seção 4: Micoplasmas (0 questão)
32. Doenças causadas por micoplasmas (0 questão)
Seção 5: Clamídias (2 questões)
33. Clamídias (2 questões)
Seção 6: Bactérias e micobactérias (42 questões)
34. Bartoneloses (0 questão)
35. Botulismo (0 questão)
36. Brucelose (0 questão)
37. Cancro mole (2 questões)
38. Carbúnculo (0 questão)
39. Cólera (0 questão)
40. Coqueluche (4 questões)
41. Difteria (0 questão)
42. Doença meningocócica (2 questões)
43. Donovanose (0 questão)
44. Endocardites infecciosas (5 questões)
45. Enterobacteriose septicêmica prolongada (0 questão)
46. Estafilococcias (2 questões)
47. Estreptococcias (9 questões)
48. Febre purpúrica brasileira (0 questão)
49. Febres tifoide e paratifoide (0 questão)
50. Gangrena gasosa (0 questão)
51. Gonorreia (2 questões)
52. Hanseníase (2 questões)
53. Infecções por Haemophilus influenzae (0 questão)
54. Infecções por Moraxella catarrhalis (0 questão)
55. Infecções por Pseudomonas spp (0 questão)
56. Infecções intestinais causadas por Escherichia coli (1 questão)
57. Infecções por anaeróbios (0 questão)
58. Legionelose (1 questão)
59. Listeriose (0 questão)
60. Meningites bacterianas (1 questão)
61. Peste (0 questão)
62. Salmoneloses (0 questão)
63. Sepse (10 questões)
64. Shigeloses (0 questão)
65. Tétano (1 questão)
66. Tuberculose (0 questão)
67. Micobactérias não tuberculosas (0 questão)
68. Tularemia (0 questão)
69. Yersiniose (0 questão)
Seção 7: Espiroquetídeos (6 questões)
70. Bouba (0 questão)
71. Doença de Lyme (DL) no Brasil: Síndrome de Baggio-Yoshinari (SBY) (0 questão)
72. Febre por mordedura de rato (0 questão)
73. Leptospiroses (3 questões)
75. Sífilis (3 questões)
Seção 8: Fungos (2 questões)
76. Micoses (1 questão)
78. Aspergilose (0 questão)
79. Infecções por fungo do gênero Candida (1 questão)
80. Criptococose (0 questão)
81. Doença de Jorge Lobo (0 questão)
82. Histoplasmose (0 questão)
83. Paracoccidioidomicose (0 questão)
84. Pneumocistose (0 questão)
85. Ligomicose: mucormicose (0 questão)
Seção 9: Protozoários (26 questões)
86. Amebíase (0 questão)
87. Infecções por amebas de vida livre (AVL) (0 questão)
88. Balantidíase (0 questão)
89. Criptosporidiose e microsporidiose (0 questão)
90. Doença de Chagas: tripanossomíase americana (0 questão)
91. Giardíase (0 questão)
92. Isosporíase humana (0 questão)
93. Leishmaniose tegumentar americana (0 questão)
94. Leishmaniose visceral: calazar (3 questões)
95. Malária (2 questões)
96. Toxoplasmose (21 questões)
Seção 10: Helmintos (1 questão)
97. Ancilostomíase (0 questão)
98. Angiostrongiloidíases (0 questão)
99. Ascaridíase (1 questão)
100. Cisticercose: comprometimento do sistema nervoso central (0 questão)
101. Difilobotríase (0 questão)
102. Enterobíase (0 questão)
103. Esquistossomose mansônica (0 questão)
104. Estrongiloidíase (0 questão)
106. Filaríases (0 questão)
107. Hidatidose: equinococoses (0 questão)
108. Lagoquilascaríase (0 questão)
109. Larva Migrans visceralis: toxocaríase humana (0 questão)
110. Paragonimíase (0 questão)
111. Teníase (0 questão)
112. Tricocefalíase (0 questão)
113. Triquinelose (0 questão)
Seção 11: Ectoparasitas (1 questão)
114. Ectoparasitoses (1 questão)
Seção 12: Síndromes infecciosas de importância clínica (23 questões)
115. Abordagem de pacientes neutropênicos febris (1 questão)
116. Adenomegalias febris (0 questão)
117. Diarreia na infância (4 questões)
118. Doença inflamatória pélvica aguda (0 questão)
120. Hepatoesplenomegalias febris (0 questão)
121. Infecção puerperal (1 questão)
122. Infecções abdominais e peritoneais (4 questões)
123. Infecções do trato genital inferior feminin (5 questões)
124. Infecções de ossos e articulações (0 questão)
125. Infecções urológicas: uretrites-prostatites-epididimites e orquites (0 questão)
126. Infecção urinária (3 questões)
127. Infecções otorrinolaringológicas (0 questão)
128. Pneumonias bacterianas (3 questões)
129. Infecções cardiológicas (2 questões)
Seção 13: Temas relacionados à infectologia (0 questão)
130. Acidentes por venenos e animais peçonhentos (0 questão)
131. Doenças transmissíveis por sangue em hemoterapia (0 questão)
132. Cárie dentária (0 questão)
Descrição do Produto:
- Banco de Questões MED de amostra contendo 177 questões sobre Infectologia no formato Word, organizado segundo o Tratado de Infectologia de Veronesi (2015).
Por que usar um banco de questões?
Diversos estudos comprovam a eficácia do uso de banco de questões para aprimorar o ensino. O pesquisador Henry L. Roediger III conduziu vários estudos na área de ciência cognitiva da aprendizagem. O uso de testes com questões de múltipla escolha contribue fortemente para a retenção a longo prazo. Infelizmente, os livros de medicina raramente contém questões. A plataforma Questões MED surgiu para sanar essa lacuna.
Conheça nossos catálogos:
Imagine ter acesso a milhares de questões organizadas de acordo com os mais recentes tratados médicos. Tudo em formato Word totalmente editável. Nossos catálogos oferecem essa vantagem exclusiva. Encontre rapidamente questões específicas relacionadas a qualquer capítulo ou tópico do livro.
Ganhe produtividade na elaboração de provas e listas de exercício. Otimize o tempo para preparar suas avaliações com os nossos catálogos. Tenha em mãos um recurso para aperfeiçoar sua prática docente.
Características deste catálogo:
- Organização Estruturada: Catálogo dividido em 126 capítulos e 976 tópicos.
- Fonte Confiável de Questões: Questões selecionadas de provas de Residência Médica e Concursos Públicos para médicos.
- Banco de Questões Recentes: Mais da metade das questões são de provas realizadas de 2018 em diante.
- Classificação e Sequenciamento: Questões agrupadas sistematicamente de acordo com o conteúdo do Tratado de Infectologia de Veronesi (2015).
- Gabaritos Destacados: Cada questão possui gabarito indicado em negrito.
- Formato Acessível e Editável: Todo o conteúdo no formato Word (.docx).
- Acesso definitivo: Sem assinaturas ou mensalidades. Após o pagamento, você terá o link para o download do catálogo.
Ficou com alguma dúvida? Entre em contato conosco aqui.
Referências
- Larsen, Douglas P., Andrew C. Butler, and Henry L. Roediger III (2008). “Test‐enhanced learning in medical education.” Medical education 42(10), 959-966.
- Roediger, H. L., & Butler, A. C. (2011). “The critical role of retrieval practice in long-term retention.” Trends in Cognitive Sciences, 15(1), 20-27.
- Butler, A. C., & Roediger, H. L. (2007). “Testing improves long-term retention in a simulated classroom setting.” European Journal of Cognitive Psychology, 19(4-5), 514-527.

Avaliações
Ainda não há avaliações